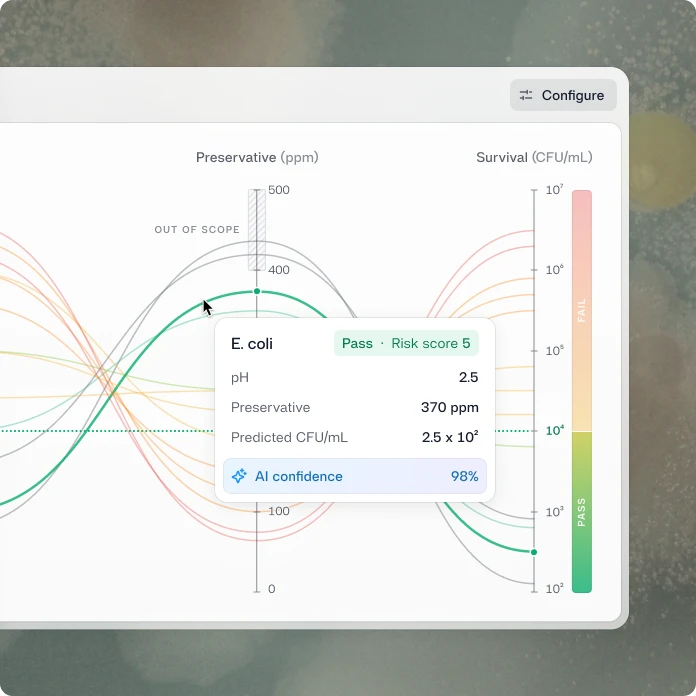

Labs are answering the same questions on repeat
Slow release cycles
Launches and reformulations queue for incubation windows that don't need to run at full length – or at all. Time your product doesn't have.
Redundant testing
A minor ingredient change shouldn't mean starting from scratch. But without a way to draw on what you already know, it usually does.
Knowledge trapped in notebooks
Years of microbiology data sits in spreadsheets and LIMS exports. Structured enough to store, too fragmented to learn from.
Headcount scales with volume
More products, more variants, more markets. The only lever available today is more people. That's not a viable strategy.
Stop testing everything. Start knowing what to test.
Reshape's predictive models translate your experimental history into formulation risk scores, so your scientists can focus their time on experiments and decisions that actually need their expertise.

Formulation self-service
Reshape scores formulation risk instantly, so scientists can test ideas independently. Lab capacity stays reserved for what genuinely needs it.

Microbiology copilot
Reshape surfaces the experiments that matter and helps you design them, so your scientists spend their expertise on real challenges, not routine confirmation work.

Portfolio management
Simulate how ingredient, packaging, or regulatory changes land across every product — before a single test is run. Get ahead of risk, not behind it.
This is what it feels like to have an answer in seconds.
Design a preservative challenge, adjust pH, organism, and preservative level — and see predicted survival outcomes in real time. This is a glimpse of where Reshape is headed.
Try our interactive prototype and explore for yourself.
This example uses beverage preservation, but the approach works across many applications. If you'd like to explore what this could look like for you, we’d be happy to talk
Start in an afternoon.
Connect your historical data and run your first prediction before end of day. No model training, no setup overhead.
Upload your historical data
Bring your existing microbiology data into Reshape. The platform works with what you have.
Check your data readiness
See how much predictive power your data already holds and where the gaps are.
Run your first prediction
Set up a validation experiment and get your first formulation recommendation instantly.
Let the model improve itself
Every new experiment makes Reshape smarter. Connect Reshape devices to close the loop automatically — structured, timestamped, and consistent.

